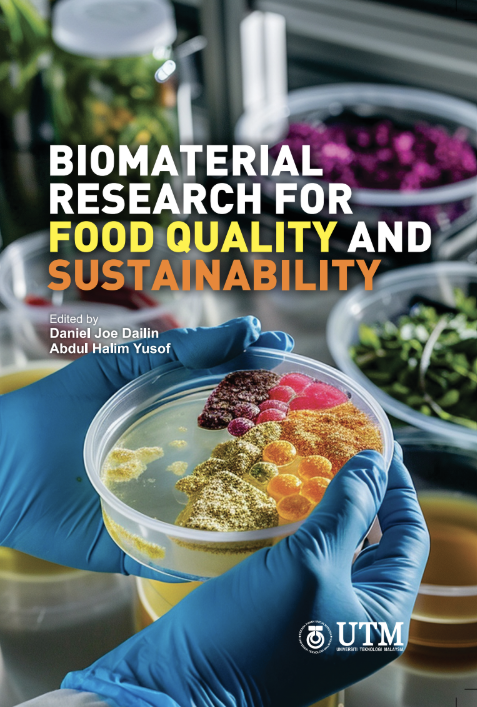
Biomaterial Research for Food Quality and Sustainability

Description
With an emphasis on sustainable alternatives and industry breakthroughs, this book offers a thorough examination of cutting-edge methods in food science and technology. It starts off by going over the use of nutrient-rich microalgae called spirulina that have been microencapsulated as a sustainable source of protein. By using this method, spirulina becomes more stable and bioavailable, which makes it appropriate for use in culinary applications. The second chapter addresses the difficulties associated with waste management in the food business and places an emphasis on the valuation of industrial and agricultural waste. The application of probiotics in shrimp farming is highlighted in the third chapter, which also shows how they can enhance the growth, health, and resistance to disease of shrimp. In the fourth chapter, new techniques for guaranteeing food safety and quality are covered together with developments in food quality analysis. The fifth chapter highlights the economic, environmental, and nutritional advantages of growing Moringa oleifera in Malaysia. Lastly, the book explores the antioxidant and phenolic content of seaweed, emphasising its uses in functional meals and health benefits. Overall, this book is an invaluable tool for food science researchers, professionals, and students, providing insights into quality, nutrition, and sustainable food production.